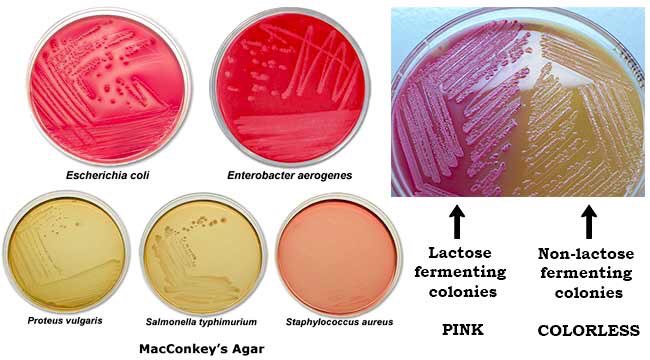
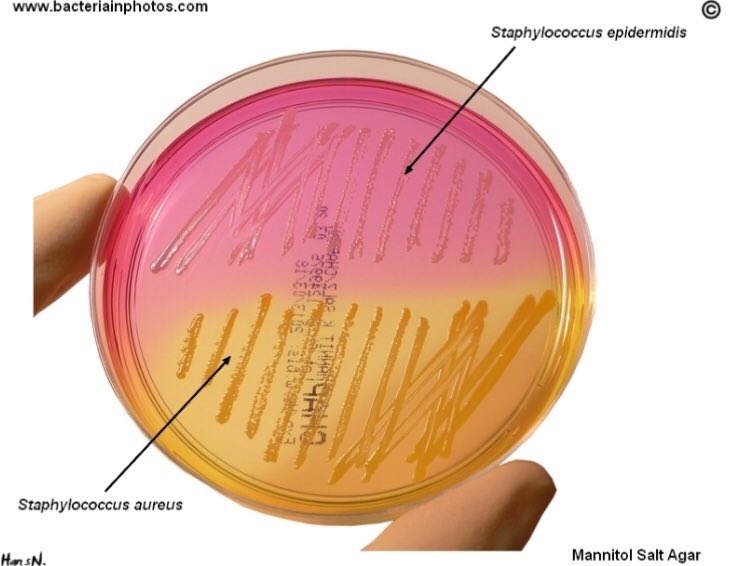

أهلاً بالجميع
ثريد اليوم عن الاوساط الزراعية
Culture Media
تستخدم لعزل البكتيريا في صوره نقيه لكي يتم تحديد نوع البكتيريا ودراسة تفاعل البكتيريا مع المضادات الحيويه
وبيفيد كثير طلاب الامتياز واللي يشتغلون بقسم الميكروبيولوجي
يلا نبدا 😍😍💪🏻
#لاب_زون #مختبرات_طبية
ثريد اليوم عن الاوساط الزراعية
Culture Media
تستخدم لعزل البكتيريا في صوره نقيه لكي يتم تحديد نوع البكتيريا ودراسة تفاعل البكتيريا مع المضادات الحيويه
وبيفيد كثير طلاب الامتياز واللي يشتغلون بقسم الميكروبيولوجي
يلا نبدا 😍😍💪🏻
#لاب_زون #مختبرات_طبية
اتمنى اني افدت واستفدوا واستمتعتوا بالقراءة
بالتوفيق للجميع.
بالتوفيق للجميع.
Loading suggestions...